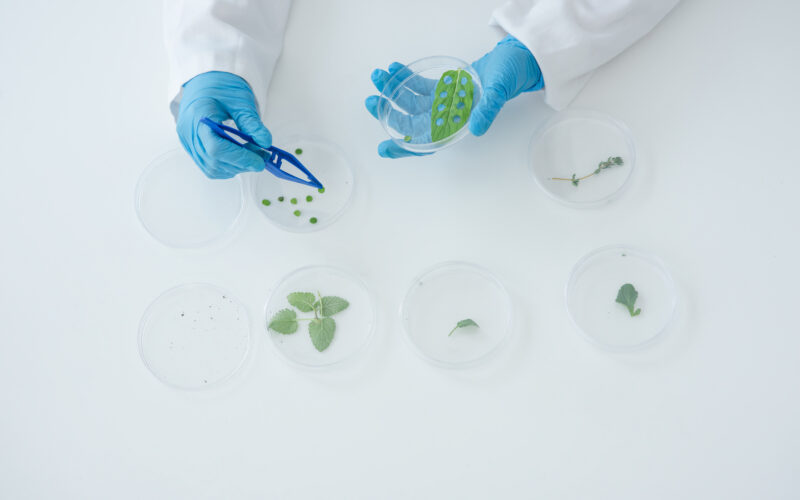

Tonix Pharmaceuticals Holding Corp. (NASDAQ:TNXP) is a clinical-stage biopharmaceutical company headquartered in Chatham, New Jersey, dedicated to discovering, developing, and commercializing innovative therapies that address serious and unmet medical needs in pain management, neurology, psychiatry, infectious diseases, and immunology. Founded in 2007, Tonix has steadily evolved from a niche CNS research firm into a diversified biotech company with a growing portfolio of product candidates targeting both acute and chronic conditions. Its mission is grounded in developing transformative medicines that improve quality of life for patients while tackling conditions that often lack effective treatment options.
Over the past decade, Tonix has become best known for its work in central nervous system (CNS) disorders and chronic pain, particularly with its flagship product, Tonmya (cyclobenzaprine HCl sublingual tablets). This treatment, which recently received FDA approval for fibromyalgia, represents the first new therapeutic option for the condition in over 15 years. Fibromyalgia affects millions of people worldwide, and Tonmya’s novel sublingual delivery method allows for more efficient absorption, reduced side effects, and improved sleep quality—an essential factor in treating the widespread pain and fatigue associated with the disease. This achievement marks a turning point for Tonix, transforming it from a development-stage biotech into a commercial-stage pharmaceutical company with revenue potential and a validated regulatory pathway.
Tonix’s scientific focus extends beyond fibromyalgia. Its diversified pipeline includes multiple clinical and preclinical candidates aimed at neurological disorders, autoimmune diseases, organ transplant rejection, substance abuse, and infectious diseases. Among its most promising assets are TNX-1500, a monoclonal antibody targeting the CD40-ligand pathway for autoimmune conditions and organ transplant rejection; TNX-801, a live-virus vaccine designed for protection against smallpox and mpox; and TNX-1300, a recombinant enzyme therapy being developed as a treatment for acute cocaine intoxication. These programs underscore Tonix’s balanced approach to innovation—combining CNS therapeutics with immunology and biodefense to create multiple avenues for long-term growth.
The company’s R&D strategy is distinguished by its emphasis on proprietary formulations and delivery technologies. Tonix utilizes a sublingual delivery platform to enhance pharmacokinetics and improve patient compliance, especially for drugs targeting chronic neurological and pain conditions. Its focus on oral and sublingual formulations reflects a broader trend toward patient-friendly therapies that reduce systemic exposure and side effects while maintaining efficacy. In addition, Tonix’s leadership team—led by CEO and founder Dr. Seth Lederman—brings deep experience in clinical research, immunology, and pharmaceutical commercialization. Under his direction, Tonix has advanced from early proof-of-concept trials to multiple late-stage studies, with an expanding U.S.-based research and manufacturing footprint designed to support both clinical development and eventual large-scale production.
Tonix also plays a vital role in national public health preparedness. Its infectious disease division is actively developing next-generation vaccines and antiviral agents under partnerships and grant programs with U.S. government agencies, including the Department of Defense and the National Institutes of Health. This biodefense focus not only diversifies its portfolio but also provides opportunities for non-dilutive funding and long-term contracts that can strengthen its financial foundation. The company’s work on TNX-801, a live-virus vaccine platform derived from synthetic horsepox, exemplifies this commitment—offering a modern approach to smallpox prevention and rapid pandemic response capabilities.
Financially, Tonix has maintained a flexible capital strategy to fund its research initiatives, relying on a combination of equity offerings, institutional partnerships, and government collaborations. The approval of Tonmya has created new revenue opportunities, setting the stage for future profitability as commercialization ramps up. Despite typical biotech-sector volatility, Tonix’s expanding pipeline, clinical milestones, and validated regulatory experience provide a strong basis for long-term value creation.
Today, Tonix Pharmaceuticals stands at the intersection of science, innovation, and unmet medical need. From its pioneering work in fibromyalgia to its development of next-generation immunotherapies and vaccines, the company continues to position itself as a leader in patient-centered innovation. Its diverse research portfolio, robust clinical infrastructure, and growing commercial presence reflect a maturing biopharma enterprise committed to reshaping the landscape of chronic disease treatment and public health defense.
FDA Approval of Tonmya: A Decade in the Making
Tonmya’s approval is the culmination of nearly a decade of persistent development, clinical testing, and regulatory engagement. It is the first new FDA-approved treatment for fibromyalgia in over 15 years, addressing a condition that affects an estimated 4 million Americans. Tonmya (cyclobenzaprine HCl sublingual tablets) offers a unique oral, under-the-tongue delivery mechanism that allows for faster absorption and potentially improved tolerability compared to traditional oral formulations.
This is particularly meaningful because fibromyalgia—characterized by widespread pain, fatigue, and sleep disturbances—has long been underserved by the pharmaceutical industry. Existing treatments such as Lyrica and Cymbalta often fail to deliver consistent relief, leaving millions searching for better options. Tonmya’s mechanism, combined with Tonix’s focus on improving sleep quality as a therapeutic lever, represents a differentiated approach to treating the disorder.
According to early data from Tonix’s Phase 3 RELIEF and RESILIENT trials, patients receiving Tonmya showed statistically significant improvements in both pain and sleep disturbance scores. The drug’s approval solidifies Tonix’s credibility in central nervous system (CNS) drug development and gives the company its first commercial foothold after years of R&D-driven losses.

CHECK THIS OUT: Corcept (CORT) Skyrockets 1,534% in 10 Years and Immuneering (IMRX) Reports 86% 9-Month Survival in Pancreatic Cancer.
Market Opportunity and Commercial Potential
The fibromyalgia market is both large and fragmented, representing a massive commercial opportunity. Analysts estimate that the total addressable market for effective fibromyalgia treatments in the U.S. exceeds $2 billion annually, with few new entrants in recent years. Tonmya’s approval positions Tonix to capture a meaningful share of this underserved population.
Because Tonmya is the first new therapy in over a decade and provides a novel delivery method, prescriber interest and patient adoption could ramp quickly. The company’s initial focus will likely be on educating physicians and leveraging digital patient outreach to drive awareness. However, as analysts at Seeking Alpha have noted, the commercial rollout will not come without challenges. Edmund Ingham, a biotech research leader at Seeking Alpha, called the approval a “mixed bag,” noting that while Tonmya’s approval is a major win, its safety profile may pose some headwinds in securing rapid market penetration.
Despite that caveat, Tonmya’s benefits in tolerability and efficacy—paired with its novel formulation—could make it the first-line therapy of choice for a substantial subset of fibromyalgia patients.
Funding the Launch: Dilution Concerns and Market Sentiment
While the FDA approval is undoubtedly transformative, Tonix’s next major test will be commercial execution. Like most small biotech firms entering commercialization, Tonix will need significant capital to fund its salesforce, marketing initiatives, and post-approval studies. Analysts expect the company will need to raise fresh capital through a secondary stock offering, which could be dilutive to current shareholders.
Ingham and other analysts have highlighted that if Tonix intends to pursue a “big commercial launch,” raising additional funds is virtually unavoidable. This is not unusual for emerging pharma companies transitioning to the commercial phase—many firms opt for equity financing shortly after approval to ensure launch success. However, the timing and pricing of any potential offering will be critical in determining whether TNXP’s stock stabilizes or experiences continued volatility.
Even so, the long-term bullish argument rests on the idea that near-term dilution could be outweighed by the longer-term revenue potential of Tonmya and its broader pipeline. If Tonix executes efficiently and achieves even a fraction of projected sales targets, the valuation upside from current depressed levels could be significant.
Beyond Tonmya: A Deep and Diversified Pipeline
While Tonmya’s FDA approval has captured the spotlight, Tonix’s broader pipeline is rich with potential catalysts across immunology, infectious disease, and neuroscience. The company continues to advance TNX-801, a single-dose live virus vaccine candidate for smallpox and mpox, which has demonstrated robust immune responses in preclinical models. In addition, TNX-1500, a monoclonal antibody targeting the CD40 ligand, is being developed to prevent organ transplant rejection and treat autoimmune diseases.
Tonix is also pushing ahead with TNX-1300, a biologic enzyme therapy for acute cocaine intoxication, which has already received Breakthrough Therapy Designation from the FDA. These programs represent multiple “shots on goal” that could generate non-dilutive partnership opportunities or grant funding, particularly in biodefense and public health.
This diversified development strategy offers investors a form of built-in risk mitigation—if Tonmya’s commercial rollout faces early hurdles, Tonix still has other value-driving assets in its pipeline.
Analyst Views: Short-Term Caution, Long-Term Optimism
The mixed market reaction to Tonmya’s approval reflects both excitement and skepticism among investors. Bulls point to the company’s growing validation, expanding pipeline, and large market potential, while bears remain wary of financial strain and execution risk. However, history shows that many biotech firms entering commercialization experience initial volatility before stabilizing once revenue begins to materialize.
The recent 20% dip in TNXP shares appears to be more of a “sell-the-news” event than a reflection of the company’s fundamentals. The stock’s initial 19% post-approval surge reflected market enthusiasm, but as traders locked in profits and short-term speculators exited, the price adjusted downward. Fundamentally, the approval itself remains a massive de-risking event that could set the stage for a multi-year growth cycle if Tonix successfully executes its launch plan.
As institutional investors reassess TNXP’s valuation in light of its new commercial status, the next few quarters will be critical. Prescription growth, early sales data, and any updates on pipeline progress will likely serve as key catalysts for share re-rating.
Conclusion: Tonix Steps Into a New Era
Tonix Pharmaceuticals’ FDA approval for Tonmya marks the most significant milestone in its corporate history. Despite short-term market turbulence and expected dilution risk, the approval transforms Tonix from a speculative biotech into a revenue-generating company with long-term growth prospects. The unmet medical need in fibromyalgia, the first-mover advantage in a stagnant therapeutic field, and a diverse development pipeline make a strong case for Tonix as an underappreciated turnaround story in the small-cap biotech sector.
If Tonix executes its commercialization strategy effectively—while managing its capital structure prudently—the company could emerge as a formidable player in CNS and pain management therapeutics. The path ahead remains challenging, but the groundwork has been laid for a potential multi-year recovery and value creation phase. For long-term investors with an appetite for high-risk, high-reward biotech plays, Tonix’s post-approval phase could represent an inflection point worth watching closely.
READ ALSO: Tiziana (TLSA) Surges 143% in 2025 and Immuneering (IMRX) Reports 86% 9-Month Survival in Pancreatic Cancer.